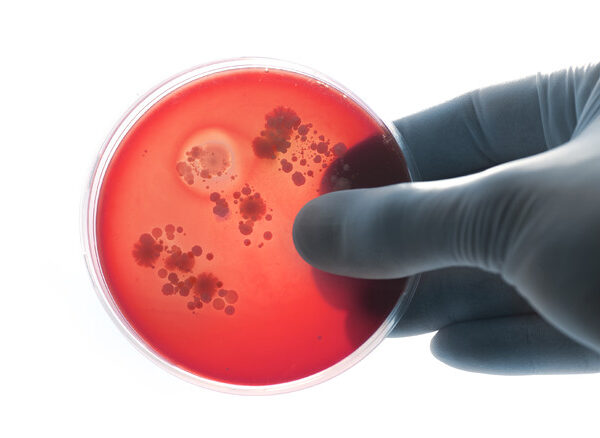

Dolori addominali, spossatezza e sanguinamenti: sono i disturbi più comuni tra chi soffre di malattie infiammatorie croniche intestinali, condizione che colpisce 250 mila italiani, soprattutto giovani, tanto che una diagnosi su 4 riguarda un bambino. E per 7 pazienti su 10 che ne soffrono diventa difficile frequentare la scuola o o il lavoro. E’ il quadro che emerge dall’indagine ‘Better: Bisogni Assistenziali, Lavorativi, Legali e Sociali’ per la cura delle malattie infiammatorie croniche dell’intestino, presentata da Amici Italia in occasione della Giornata mondiale. “Patologie come la malattia di Crohn e la colite ulcerosa si presentano con periodi di riacutizzazione alternati a fasi di remissione e di cui non si conosce la causa – spiega Valentina Ferracuti, presidente Amici Italia -. L’età in cui più frequentemente…